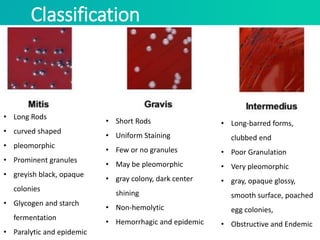
Classification
• Long Rods
• curved shaped
• pleomorphic
• Prominent granules
• greyish black, opaque
colonies
• Glycogen and starch
fermentation
• Paralytic and epidemic
• Short Rods
• Uniform Staining
• Few or no granules
• May be pleomorphic
• gray colony, dark center
shining
• Non-hemolytic
• Hemorrhagic and epidemic
• Long-barred forms,
clubbed end
• Poor Granulation
• Very pleomorphic
• gray, opaque glossy,
smooth surface, poached
egg colonies,
• Obstructive and Endemic

Embed presentation
Downloaded 215 times





















Corynebacterium diphtheriae is the bacterium responsible for diphtheria, a serious infectious disease characterized by a potent exotoxin that can cause severe respiratory complications and systemic effects. The pathogenesis of diphtheria involves its ability to colonize and produce diphtheria toxin, which can lead to life-threatening conditions. Control measures include immunization with diphtheria toxoid and antibiotics, with prompt administration of antitoxin being crucial to reduce mortality rates.